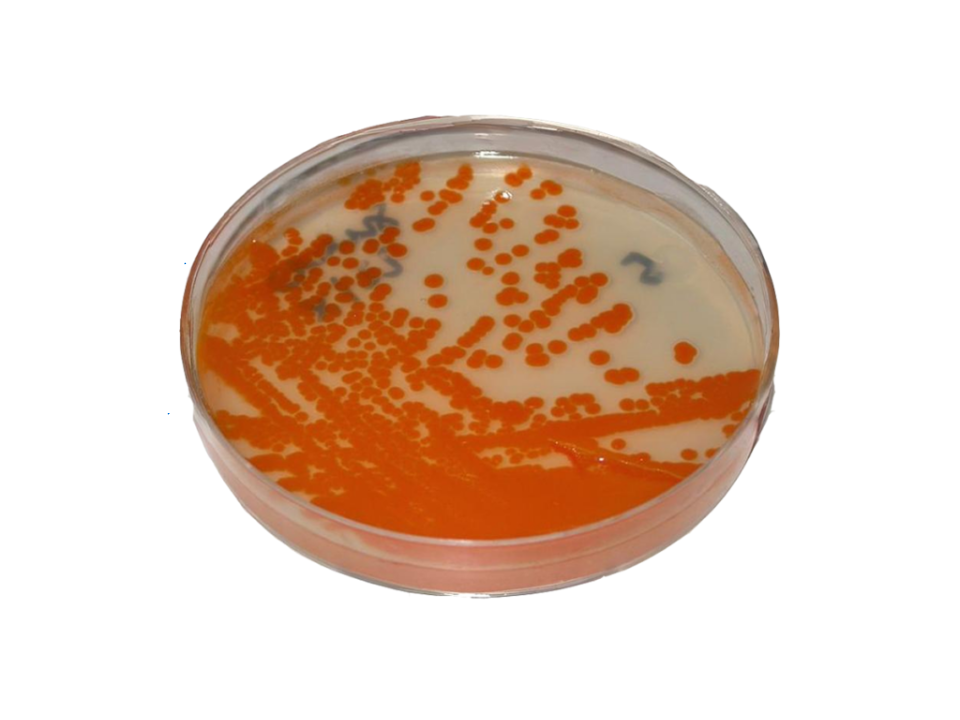
Bactéria comum em gestantes está circulando mais e com maior resistência aos antibióticos

Pesquisadores do Instituto de Física de São Carlos (IFSC) da USP e Universidade Federal da Paraíba (UFPB) fizeram uma descoberta preocupante sobre a bactéria Streptococcus agalactiae, conhecida popularmente como estreptococo do grupo B (GBS). Os cientistas identificaram uma grande variedade genética entre amostras bacterianas, ou seja, existem muitas versões diferentes da mesma bactéria circulando, algumas delas com características que as tornam mais perigosas, como a capacidade de se espalhar mais facilmente pelo corpo, causar doenças graves ou resistir ao efeito de antibióticos.
Presente naturalmente no organismo, principalmente no intestino e no trato genital feminino, a Streptococcus agalactiae pode causar infecções graves em recém-nascidos, gestantes, idosos e pessoas com baixa imunidade. Parte das variantes encontradas no trabalho são alvos de vacinas em fase de desenvolvimento, porém os pesquisadores enfatizam a necessidade de maior vigilância da circulação da bactéria. O estudo é descrito em artigo publicado na revista científica Pathogens.
A pesquisa analisou 101 amostras da bactéria coletadas na cidade de João Pessoa (PB) entre 2018 e 2022, com o principal objetivo de entender melhor como essa bactéria tem se comportado e evoluído na região. Entre as amostras analisadas, mais de 80% apresentaram resistência a algum antibiótico, principalmente à tetraciclina. Além disso, quase 9% eram resistentes à eritromicina, e cerca de 7% não respondiam à clindamicina, outro medicamento usado especialmente quando o paciente é alérgico à penicilina. Uma das cepas analisadas (MA06) chamou atenção por acumular várias formas de resistência, enquanto outras cepas apresentaram semelhanças com bactérias normalmente encontradas em animais. Isso indica que a troca de material genético entre bactérias humanas e animais pode estar acontecendo com mais frequência do que se pensava.
Outra descoberta marcante do estudo foi a identificação de uma linhagem inédita da bactéria, chamada de ST1983. Essas novas variantes apresentam características genéticas que as tornam diferentes das versões mais comuns da bactéria encontradas em humanos. Parte do seu material genético é semelhante ao de bactérias presentes em animais, como vacas e porcos. Isso levanta a possibilidade de que essas novas versões estejam conseguindo circular entre humanos e animais, o que aumenta o risco de transmissão e dificulta o controle da doença. Os autores do estudo destacam que, se essas linhagens continuarem a se adaptar, elas podem se tornar ainda mais resistentes a tratamentos e mais capazes de provocar surtos.
Vacinas e vigilância
Apesar da grande variedade de tipos da bactéria encontrados, a maioria deles estaria coberta pelas vacinas que estão atualmente em fase de desenvolvimento. Essas vacinas são projetadas para proteger contra as cepas mais frequentes, especialmente os que mais causam doenças em recém-nascidos e gestantes. No entanto, duas amostras estudadas não se enquadraram em nenhuma das categorias conhecidas, o que reforça a necessidade de manter a vigilância sobre o comportamento da bactéria, especialmente em um país com grande biodiversidade como o Brasil, onde a interação entre humanos e animais é intensa, tanto em áreas rurais quanto urbanas.
Para os cientistas, a descoberta exige atenção das autoridades de saúde. A presença de bactérias resistentes a medicamentos e com origem possivelmente em animais representa um desafio adicional para hospitais e maternidades. Hoje já estão estabelecidos protocolos de prevenção fundamentados na aplicação de antibióticos durante o parto para evitar que o bebê seja infectado, mas, com o aumento da resistência, essa estratégia pode deixar de ser eficaz no futuro. Além disso, o estudo reforça a importância de se investir em vacinas contra a bactéria e em pesquisas que monitorem seu comportamento em diferentes regiões do País. A prevenção é fundamental, especialmente porque as infecções por Streptococcus agalactiae podem causar complicações sérias nos recém-nascidos, como pneumonia, meningite e sepse (infecção generalizada).
“Embora desde a década de 1990 existam recomendações internacionais para a triagem da colonização materna e o uso de antibióticos preventivos durante o parto, essas diretrizes ainda não foram incorporadas ao pré-natal de baixo risco no Brasil. Isso significa que muitas gestantes não têm acesso garantido à prevenção da infecção neonatal pelo estreptococo do grupo B”, destaca o professor Vinícius Pietta Perez, da UFPB. “Nesse contexto, nosso estudo contribui para identificar as estratégias mais eficazes de prevenção e pode apoiar, futuramente, a implementação de vacinas direcionadas aos sorotipos capsulares mais prevalentes no País.”
A pesquisa feita na Paraíba revela um cenário que pode estar se repetindo em outras partes do Brasil e do mundo. A bactéria Streptococcus agalactiae, até então considerada relativamente controlada, está mostrando sinais de evolução e adaptação que exige novas formas de prevenção, diagnóstico e tratamento. “O avanço da ciência, com apoio à vacinação e à vigilância genômica, será essencial para garantir a saúde de gestantes, bebês e outros grupos vulneráveis nos próximos anos”, afirma a professora Ilana Lopes Baratella da Cunha Camargo do IFSC, pesquisadora principal que assina o artigo. “Atualmente, nós devemos pensar sempre dentro do contexto de ‘Uma só saúde’, levando em consideração a interação de humanos, outros animais e o meio ambiente. Streptococcus agalactiae é uma das bactérias que pode transitar entre humanos e outros animais, como caprinos e bovinos.”
Segundo a professora do IFSC, há uma preocupação muito grande quanto às alternativas de tratamento para infecções causadas por essa bactéria quando ela apresenta resistência à penicilina. “Por isso, desde 2024, estreptococo do grupo B está na lista de patógenos prioritários emitida pela Organização Mundial da Saúde (OMS) para a busca de novos fármacos ou alternativas de tratamento”, ressalta. “Estudos de vigilância e genômica são essenciais para o monitoramento de bactérias como essa.”
*Da Assessoria de Comunicação do IFSC, adaptado para o Jornal da USP
Matéria – Jornal da USP
Texto: Redação*
Arte: Jornal da USP
Imagem – Cultura de laboratório da bactéria estreptococo do grupo B (GBS); entre as amostras analisadas, mais de 80% apresentaram resistência a algum antibiótico – Foto: Wikimédia